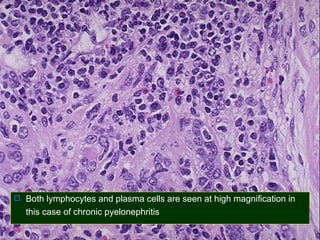
 Both lymphocytes and plasma cells are seen at high magnification in

this case of chronic pyelonephritis
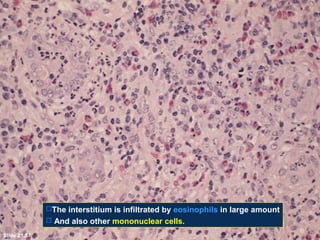
The interstitium is infiltrated by eosinophils in large amount
 And also other mononuclear cells.
Slide 21.57

This document discusses disease affecting the renal tubules and interstitium. It begins by explaining that tubular injury often also involves the interstitium and can be inflammatory, as seen in interstitial nephritis, or ischemic, as seen in acute tubular necrosis. The document then goes on to describe various specific diseases in more detail, including tubulointerstitial nephritis of infectious and non-infectious origin, acute and chronic pyelonephritis, drug-induced interstitial nephritis, and analgesic nephropathy. It also provides morphological and clinical details of acute tubular necrosis.